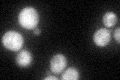
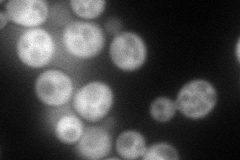
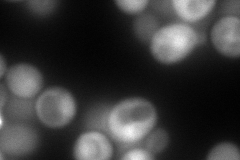
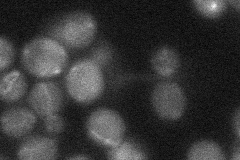
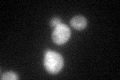
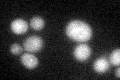

View description
Protein kinase required for signal transduction during entry into meiosis; promotes the formation of the Ime1p-Ume6p complex by phosphorylating Ime1p and Ume6p; shares similarity with mammalian glycogen synthase kinase 3-beta
Localization:
Intensity:
Fold change:
Significance:
-
C’ GFP library in SD
cytosol35.04 -
N' NOP1pr-GFP in SD
cytosol,punctate98.7371 -
N' TEF2pr-mCherry in SD
nucleus217.336 -
N' NATIVEpr-GFP in SD
below threshold22.8836 -
N' TEF2pr-VC and Cyto-VN in SD

cytosol43.6494 -
C’ GFP library in SD+DTT
cytosol35.371No -
C’ GFP library in SD+H2O2

cytosol33.320.95No -
C’ GFP library in Starvation Media
cytosol66.671.9Yes -
C’ GFP library on the background of Pup2-DaMP

cytosol -
C’ GFP library on the background of CCT mutant

cytosol45.32011.29308No
